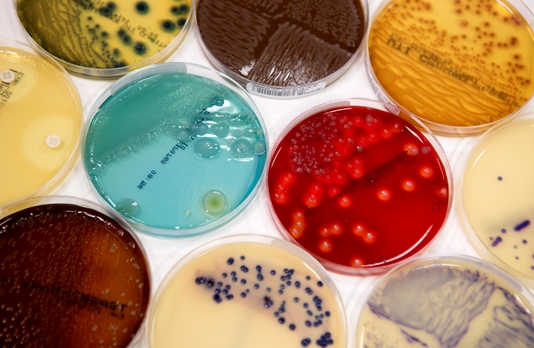
Wat doet een Deskundige Infectiepreventie?

Wat doet een Deskundige Infectiepreventie?
Als Deskundige Infectiepreventie ben jij dé inhoudelijke specialist op het gebied van hygiëne en infectiepreventie binnen de zorg. Jij adviseert organisaties over het voorkomen van infectierisico’s en ziet erop toe dat beleid, richtlijnen en werkprocessen correct worden toegepast. Of je nu werkt in een ziekenhuis, verpleeg- en verzorgingstehuis, GGD of zelfstandige kliniek: jij zorgt voor veilige zorgomgevingen.
Tijdens het werken als deskundige infectiepreventie voer je audits uit, neem je deel aan infectiepreventiecommissies en stel je beleid en protocollen op. Daarnaast geef je scholingen en praktische adviezen aan zorgprofessionals. Veel deskundigen infectiepreventie werken zelfstandig op verschillende locaties, waardoor geen dag hetzelfde is. Dankzij jouw expertise ondersteun je zorginstellingen bij capaciteitsproblemen en draag je direct bij aan het terugdringen van zorginfecties.